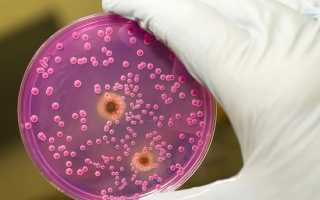
Анальный кандидоз: причины и лечение

Врачи отмечают, что анальный кандидоз является распространенной проблемой, особенно среди людей с ослабленным иммунитетом. Симптомы, такие как зуд, жжение и дискомфорт в области ануса, могут значительно ухудшить качество жизни пациента. Специалисты подчеркивают важность своевременной диагностики и лечения, так как запущенные случаи могут привести к более серьезным осложнениям. Врачи рекомендуют избегать самолечения и обращаться за медицинской помощью при первых признаках заболевания. Лечение обычно включает противогрибковые препараты и рекомендации по изменению образа жизни, что помогает предотвратить рецидивы. Профилактика также играет ключевую роль, и врачи советуют соблюдать гигиену и укреплять иммунную систему.

Причины появления
Возбудители заболеваний являются частью условно-патогенной микрофлоры, присутствующей в организме каждого здорового человека. При наличии определенных «благоприятных» условий грибки начинают активно размножаться, что приводит к поражению стенок кишечника, прямой кишки и развитию кандидоза заднего прохода. Активация условно-патогенных микроорганизмов происходит на фоне ослабления иммунной системы.
Молочница кишечника возникает под воздействием различных факторов, которые приводят к снижению выработки полезных ферментов в кишечнике.
К числу таких факторов относятся:
- неправильное питание, анорексия;
- чрезмерное употребление сладостей и продуктов, раздражающих стенки кишечника, таких как алкоголь, кофе и специи;
- аллергические реакции;
- аутоиммунные заболевания;
- дисбаланс микрофлоры кишечника;
- заболевания эндокринной системы;
- лечение онкологических заболеваний (химиотерапия, лучевая терапия);
- заболевания крови;
- глистные инвазии;
- активная стадия туберкулеза;
- использование антибактериальных и гормональных препаратов.
| Симптом | Возможная причина | Лечение |
|---|---|---|
| Зуд и жжение в анальной области | Грибковая инфекция (Candida) | Противогрибковые мази (например, клотримазол, миконазол) |
| Боль при дефекации | Воспаление анальной области | Теплые сидячие ванны, обезболивающие мази |
| Выделения белого цвета | Разрастание грибка Candida | Противогрибковые препараты, назначенные врачом |
| Трещины в анальной области | Грибковая инфекция, травма | Заживляющие мази, диета, избегание запоров |
| Отек и покраснение анальной области | Воспаление, аллергическая реакция | Противогрибковые препараты, противовоспалительные средства |
| Дискомфорт и раздражение | Грибковая инфекция, раздражение от гигиенических средств | Изменение гигиенических привычек, мягкие очищающие средства |
Факторы появления кандидоза
Кандидоз прямой кишки, если его не лечить, может перерасти в кандидоз анального отверстия.
К причинам возникновения молочницы в области заднего прохода можно отнести:
- аллергические реакции на гигиенические средства (мыло, ароматизированные ежедневные прокладки);
- недостаточную гигиену половых органов;
- повышенное потоотделение;
- избыточную массу тела;
- раздражение кожи синтетическими тканями нижнего белья;
- ношение тесного белья (например, стрингов);
- проктологические заболевания (геморрой, трещины, нарушения стула).
Особенно уязвимы к кандидозу анальной области представители ЛГБТ-сообщества (люди, предпочитающие гомосексуальные отношения). Избежать развития молочницы возможно, если исключить или свести к минимуму влияние всех перечисленных факторов.
Анальный кандидоз — это заболевание, о котором многие предпочитают не говорить открыто, однако обсуждения на форумах и в социальных сетях показывают, что проблема актуальна для многих. Люди делятся своим опытом, описывая симптомы, такие как зуд, жжение и дискомфорт. Некоторые отмечают, что заболевание часто возникает после курса антибиотиков или при ослаблении иммунной системы. В комментариях можно встретить советы по лечению, включая использование противогрибковых кремов и изменение диеты. Многие подчеркивают важность консультации с врачом, чтобы избежать осложнений. Несмотря на деликатность темы, открытое обсуждение помогает снять стигму и повысить осведомленность о заболевании.

Признаки заболевания
Симптомы кандидоза заднего прохода нередко принимают за проявления других заболеваний, таких как колит, геморрой или инфекция, вызванная паразитами. На ранних стадиях болезнь может быть трудно диагностировать, поскольку она не всегда сопровождается характерными признаками. Согласно статистике, молочница заднего прохода чаще всего встречается у новорожденных и пожилых людей.
Кандидоз анальной области проявляется следующими симптомами:
- жжение и дискомфорт в области ануса;
- жжение после дефекации;
- покраснение и отечность анальной зоны;
- мацерация — увлажнение и размягчение тканей вокруг ануса;
- зуд в области заднего прохода;
- белый жидкий налет;
- эрозивные изменения.
Кандидоз прямой кишки развивается при полном поражении слизистой оболочки кишечника и может проявляться следующими симптомами:
- боли различной интенсивности в области кишечника;
- ложные позывы к дефекации;
- изменения в стуле (запоры или поносы);
- наличие слизи или крови в кале;
- изменение цвета каловых масс.
При кандидозе кишечника могут возникать трещины в любом участке прямой кишки, что сопровождается тянущими и ноющими болями в нижней части живота. Во время дефекации пациент испытывает сильную боль внутри.
Диагностика
Диагностика кандидоза анального канала осуществляется врачом-гинекологом или урологом на основе внешнего осмотра, лабораторных исследований и, при необходимости, дополнительных обследований.
К методам обследования относятся:
- анализ крови на уровень глюкозы;
- анализ кала на наличие гельминтов;
- трижды анализ на энтеробиоз;
- бактериологический посев кала;
- посев на грибок из прямой кишки;
- сфинктерометрия — исследование функциональности сфинктера;
- определение устойчивости грибка к антибиотикам;
- консультация инфекциониста и эндокринолога.
Для достижения успешного лечения важно исключить наличие других заболеваний. Для этого пациента проверяют на ВИЧ, а в редких случаях может быть назначена колоноскопия для детального обследования кишечника.

Как лечить
Лечение кандидоза можно разделить на два типа: местное и системное. Местное лечение осуществляется с помощью мазей, тогда как системное требует применения медикаментов. Важно также следовать определенным рекомендациям по питанию, качеству продуктов, образу жизни и гигиеническим привычкам.
Процесс лечения включает в себя следующие шаги:
- Соблюдение диеты: необходимо исключить из рациона сладкие, острые, жирные, копченые и пересоленные блюда. В рацион можно включить мясные и молочные продукты, особенно кисломолочные, субпродукты, а также овощи и фрукты.
- Ношение удобного хлопкового нижнего белья.
- Соблюдение гигиенических норм после посещения туалета (рекомендуется использовать гигиенический душ или влажные салфетки). Также не стоит вытираться насухо.
Местное лечение
- Антисептические средства: «Хлоргексидин» и «Гексатидин» помогают предотвратить присоединение дополнительных инфекций.
- Противогрибковые препараты в форме гелей, свечей и мазей: «Нистатин», «Амфотерицин», «Натамицин», «Клотримазол».
- Оральные препараты: «Декамин», «Леворин», «Имидазол». Они применяются при грибковых инфекциях прямой кишки.
Народные методы
Использование травяных ванночек и других народных средств позволяет эффективно справляться с зудом и жжением в области ануса без необходимости прибегать к медикаментозному лечению.
- Для создания травяных ванночек можно использовать барвинок или мяту перечную. Для этого одну столовую ложку выбранной травы заливают кипящей водой и настаивают в течение 20 минут. Полученный настой применяют для подмывания на протяжении 10 дней.
- Череда, ромашка и кора дуба смешиваются в равных пропорциях и заливаются кипятком на 30 минут. Затем отвар добавляется в ванну. Рекомендуется принимать такие ванны в течение двух недель.
Травяные ванночки помогают уменьшить болевые и дискомфортные ощущения в области ануса, а также обладают дезинфицирующими, успокаивающими и заживляющими свойствами для раздраженных участков кожи.
Осложнения
Молочница, возникающая в кишечнике или области заднего прохода, при отсутствии надлежащего лечения и несоблюдении гигиенических норм, а также при сексуальных контактах, может быстро перерасти в генитальный кандидоз. Это заболевание затрагивает как внутренние, так и внешние половые органы.
Урогенитальный кандидоз также может поражать уретру, что является наиболее серьезной формой этого недуга. У мужчин половой кандидоз проявляется поражением головки и крайней плоти. Симптоматика как у мужчин, так и у женщин схожа: наблюдаются покраснение, белые творожистые выделения, зуд и жжение, а также эрозии после удаления белого налета и трудности с мочеиспусканием.
Заключение
При генитальном кандидозе терапия осуществляется комплексно и поэтапно. Если молочница выявлена у одного из партнеров, то на период лечения рекомендуется воздержаться от интимных отношений, а также пройти обследование второму партнеру.
Своевременное лечение анального грибка приносит хорошие результаты с минимальной вероятностью повторного появления заболевания. Важно следовать рекомендациям врача и, по возможности, исключить воздействие факторов, способствующих развитию инфекции.
Вопрос-ответ
Что такое анальный кандидоз и как он возникает?
Анальный кандидоз — это грибковая инфекция, вызванная избыточным размножением грибов рода Candida в области ануса. Он может возникнуть в результате ослабления иммунной системы, длительного применения антибиотиков, несоблюдения гигиенических норм или наличия хронических заболеваний, таких как диабет.
Какие симптомы могут указывать на наличие анального кандидоза?
Симптомы анального кандидоза могут включать зуд, жжение, покраснение и отек в области ануса, а также выделения с неприятным запахом. В некоторых случаях может наблюдаться боль при дефекации. Если вы заметили такие симптомы, рекомендуется обратиться к врачу для диагностики и лечения.
Как лечится анальный кандидоз?
Лечение анального кандидоза обычно включает применение противогрибковых препаратов, которые могут быть назначены в виде кремов, мазей или таблеток. Важно также соблюдать гигиену, избегать раздражающих веществ и, при необходимости, скорректировать диету. Консультация с врачом поможет определить наиболее подходящий план лечения.
Советы
СОВЕТ №1
Регулярно поддерживайте гигиену в области ануса. Используйте мягкие мыло и теплую воду для очищения, избегая агрессивных средств, которые могут вызвать раздражение.
СОВЕТ №2
Следите за своим рационом. Употребление продуктов, богатых пробиотиками, таких как йогурт и кефир, может помочь поддерживать здоровую микрофлору и предотвратить развитие кандидоза.
СОВЕТ №3
Избегайте длительного ношения синтетического нижнего белья. Предпочитайте хлопковые ткани, которые позволяют коже дышать и уменьшают риск развития грибковых инфекций.
СОВЕТ №4
При появлении симптомов анального кандидоза, таких как зуд или дискомфорт, не откладывайте визит к врачу. Раннее обращение за медицинской помощью поможет избежать осложнений и ускорит процесс выздоровления.